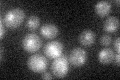
YDR520C
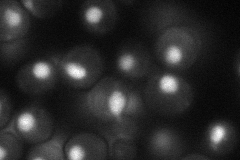
YDR520C
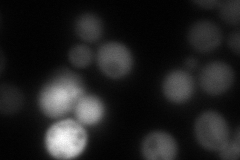
YDR520C
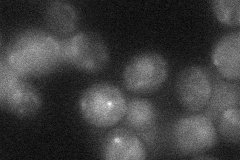
YDR520C

View description
Putative Zn(II)2Cys6 motif containing transcription factor; non-essential gene identified in a screen for mutants with increased levels of rDNA transcription; similar to S. kluyveri Urc2p involved in uracil catabolism
Localization:
Intensity:
Fold change:
Significance:
-
C’ GFP library in SD
nucleus20.07 -
N' NOP1pr-GFP in SD
nucleus40.4865 -
N' TEF2pr-mCherry in SD
cytosol134.73 -
N' NATIVEpr-GFP in SD

missing0 -
N' TEF2pr-VC and Cyto-VN in SD
below threshold24.0276 -
C’ GFP library in SD+DTT

nucleusN/AN/ANo -
C’ GFP library in SD+H2O2

technical problem0N/ANo -
C’ GFP library in Starvation Media

nucleusN/AN/AYes -
C’ GFP library on the background of Pup2-DaMP

nucleus -
C’ GFP library on the background of CCT mutant

nucleusN/AN/ANo
